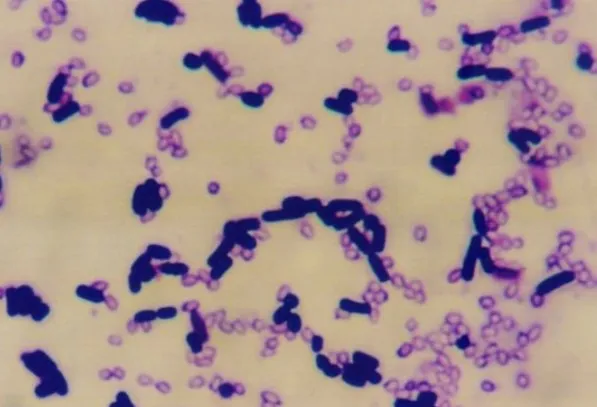
Agricultural Fertilizer Feed Use Probiotics Bacillus Pumilus Powder

Home > Products > Feed Additives > Agricultural Fertilizer Feed Use Probiotics Bacillus Pumilus Powder
Agricultural Fertilizer Feed Use Probiotics Bacillus Pumilus Powder
Agricultural Fertilizer Feed Use Probiotics Bacillus Pumilus PowderProduct NumberBacillus pumilus AppearanceYellow Brown PowderAssay98%SampleAvailableTest MethodHPLC UVActive IngredientBacillus pumilus MOQ1KGStorageKeep in cool & dry place, stay away from strong light and heatPromoting the growt......
Send Inquiry
Product Description

Agricultural Fertilizer Feed Use Probiotics Bacillus Pumilus Powder




| Product Number | Bacillus pumilus |
| Appearance | Yellow Brown Powder |
| Assay | 98% |
| Sample | Available |
| Test Method | HPLC UV |
| Active Ingredient | Bacillus pumilus |
| MOQ | 1KG |
| Storage | Keep in cool & dry place, stay away from strong light and heat |
Promoting the growth and reproduction of probiotics conlonies(such as bifidobacterium, lactobacillus and Alculigenes foecalis), inhibition on the growth and reproduction of harmful bacteria and spoilage bacteria in the intestinal tract, such as staphylococcus, candida, klebsiella, proteus, campylobacter, pseudomonas aeruginosa, escherichia coli, shigella dysenteriae and salmonella typhi, etc, as well as the reduction on the formation of animal and indoles. While the generation of harmful substances, such as ammonia, indole and hydrogen sulfide, etc will be reduce since the protein cannot be decomposed by clostridium butyricum itself.This bacterium can hydrolyze starch and degrade mannan, xylan, cellulose, etc.
 1. For aquatic animal feeding
1. For aquatic animal feedingPurify water, improving water quality and transparency, remedy pond bottom, expel toxin, keep water micro-environment balance. Promote aquaculture microflora balance in intestines, improve digestion and anti-stress ability, promote growth.
2. For planting & soil
Treatment the Polluted farmland by heavy metal(ST);
Nitrogen fixation, phosphate-solubilizing, releasing;
Enhancement of soil fertility;
Promote the prowth of crops;
Anti harmful bacterial, insect-resistant;
Avoid the soil problem by continuous cropping.


[Usage and Dosage]
Calculate content as 2×1010cfu/g content calculation, dosage of other products can be according to the actual content for conversion
1 Fermentation organic fertilizer: cooperate with other microbial powder are used together, adding amount of 100-200 g/ton
2 Configuration of organic fertilizer: use this product 200-300 g/mu and farmyard manure, chemical fertilizer or moderate fine soil after blending or topdressing, or water spray directly.


Related Category
Send Inquiry
Please Feel free to give your inquiry in the form below. We will reply you in 24 hours.












